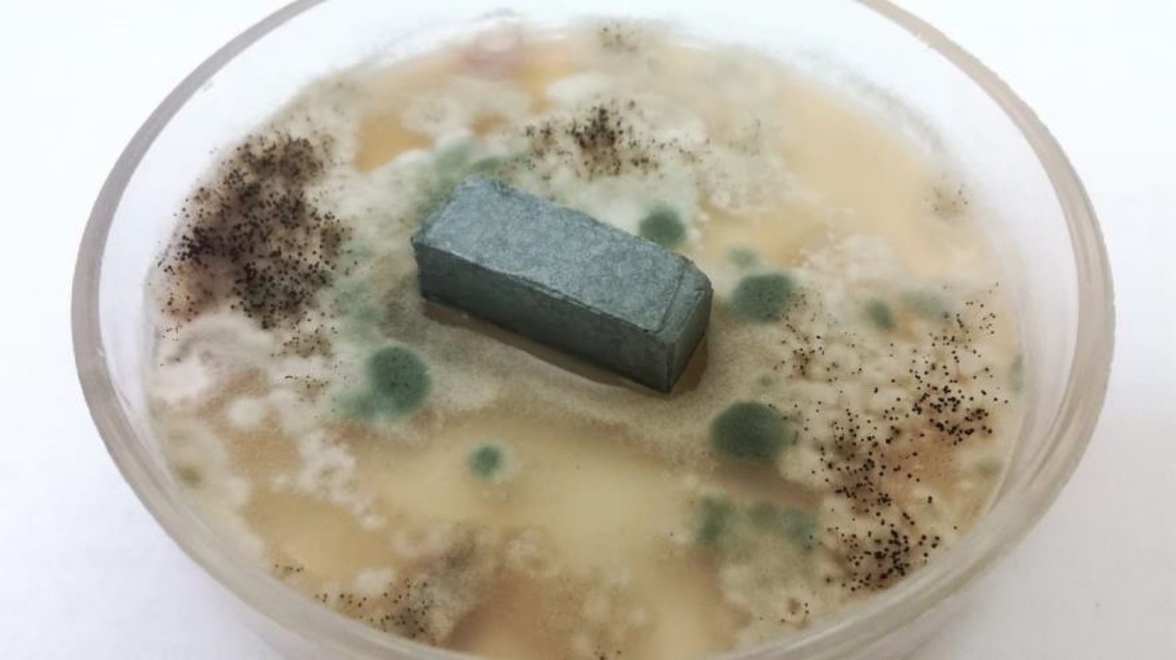
Ученые выяснили, как защитить стройматериалы от микроорганизмов, вызывающих коррозию

Важной проблемой современного строительства является биокоррозия материалов. Бактерии, лишайники и грибы поражают строительные материалы, негативно влияя не только на их внешний вид, но и на прочностные характеристики.
Разрушение поврежденных плесенью конструкций может причинить колоссальный ущерб и вызвать человеческие жертвы, а ремонт таких конструкций ведет к большим финансовым затратам. Ученые из Перми, Саранска и Нижнего Новгорода выяснили, как бактерицидные добавки влияют на стойкость стройматериалов к воздействию плесневых грибов. Исследование опубликовано в журнале International Journal for Computational Civil and Structural Engineering, том 18 №2, 2022. Разработка проведена в рамках программы стратегического академического лидерства «Приоритет 2030».
Ученые ПНИПУ, МГУ им. Н.П. Огарева и ННГУ им. Лобачевского исследовали эффективность применения биоцида «Полигексаметиленгуанидин гидрохлорид» («ПГМГ-ГХ») российского производства ООО "Альтерхим-Про". Биоцид ПГМГ-ГХ – это химическое вещество, которое эффективно используется против развития микроорганизмов в лакокрасочных материалах, предназначенных для окраски древесины. Ранее эффективность введения ПГМГ-ГХ в состав строительного материала не была исследована. Для проведения экспериментов ученые на 3d-принтере напечатали специальные формы для заливки образцов 1х1х3 и залили их заранее заготовленным раствором, сформировав маленькие блоки из цементного камня, бетона и гипсовой штукатурки. Часть образцов была без биоцида, т.е. контрольной, а часть – с добавлением биоцида в разных дозировках.
Поскольку для размножения плесени необходима питательная среда и благоприятные условия, сначала ученые заразили образцы строительных материалов спорами плесневых грибов и поместили их в стерильную чашку Петри. Эксперимент показал, что образцы сами по себе грибостойкие, и они являются питательной средой для плесневых грибов. Однако в процессе эксплуатации на поверхность строительного материала попадают различные загрязнения, которые могут быть занесены с водой и ветром, поэтому материалы должны быть не только грибостойкими, но и фунгицидными, т.е. способными останавливать рост и деление плесневых грибов.
Чтобы удостовериться, что образцы фунгицидны, ученые провели второй эксперимент. В нем материал заразили спорами плесневых грибов и поместили в чашку Петри с питательной средой для плесени. В этом случае на питательной среде должен происходить рост плесени, но если биоцидные добавки в строительном материале способны подавлять развитие плесневых грибов, то вокруг образца будет наблюдаться зона, где плесень не будет развиваться. Следовательно, такой образец способен противостоять развитию плесени на своей поверхности, что может быть актуально для конструкций, эксплуатирующихся в условиях повышенной влажности.
"Бактерицидные добавки эффективны, поскольку позволят сохранить долговечность строительных конструкций. Теперь необходимо определить оптимальные количество добавляемых в смесь биоцидных добавок, поскольку увеличение дозировки биоцида в бетоне приводит к увеличению его стоимости. Экспериментальные исследования дают большой объем данных, в дальнейшем планируется использовать нейронные сети для создания математических моделей прогнозирования долговечности строительного материала. Нейросети оказались очень хорошо приспособленными для получения зависимостей между вводимой в смесь добавкой и полученными свойствами строительного материала, т.е. для прямых корреляций «структура—свойство», – подводит итог Галина Кашеварова, доктор технических наук и заведующая кафедрой строительных конструкций и вычислительной механики ПНИПУ.
Результаты исследования актуальны и применимы на практике, они будут полезны при строительстве новых зданий и сооружений. В дальнейшем ученые планируют исследовать эффективность уменьшенных дозировок биоцидных добавок (это поможет снизить затраты на обработку стройматериалов), воздействие различных пластифицирующих добавок на биоцидные свойства бетона, влияние наномодифицированных добавок на полимерные материалы, которые тоже активно применяются в современном строительстве.